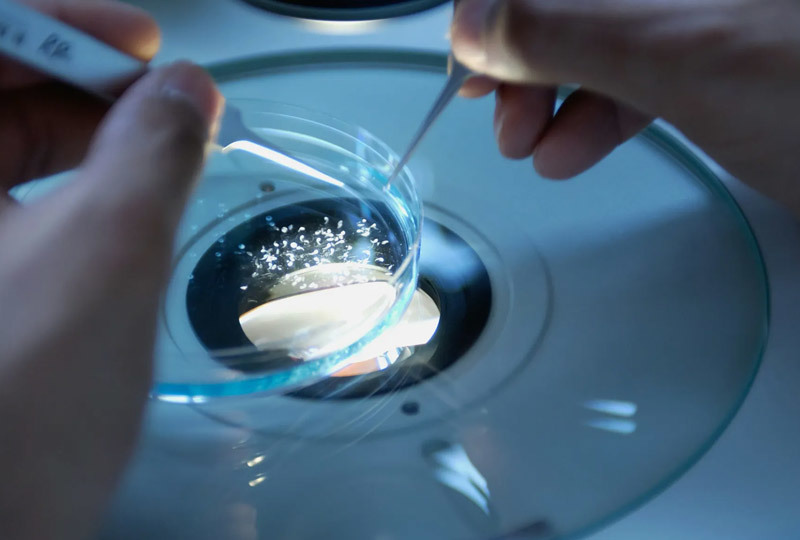
Stick To Quality Never Compromise

Science wins Infinite Future
Pushing the boundaries of life
Company
As an enterprise at the forefront of perpetual innovation, our vision is to craft a world where the energizing benefits of technology are within everyone's reach.
At the heart of our operations lies a commitment to pioneering health solutions that seamlessly blend rigorous scientific research with the latest in technological advancements, ensuring that our exceptional range of products and services enhance the well-being of people across the globe.
Championing the ethos of 'technology for good,' we stand as advocates for a healthier way of life, striving to make wellness achievable and accessible for every individual.

Supply area
Partnered Drug Factory
Client Base

Science Wins Infinite Future
Science Wins Infinite Future

Enlightenting Minds Changing The World
Enlightenting Minds Changing The World
Stick To Quality Never Compromise
Stick To Quality Never Compromise

Excellent Team
Excellent Team
International R&D System

Establishing factories globally and building an internationally oriented research and development system with a global perspective.
BIOCENTER INC.
ELMSFORD,NY 10523 USA BOSTON,MA 02115.USA
LOYAL ADVANCE LIMITED
TAI POINDUSTRIAL ESTATETAI PO.NT.HK
ファーマフーズ株式会社
京都市西京区御陵大原1-49






